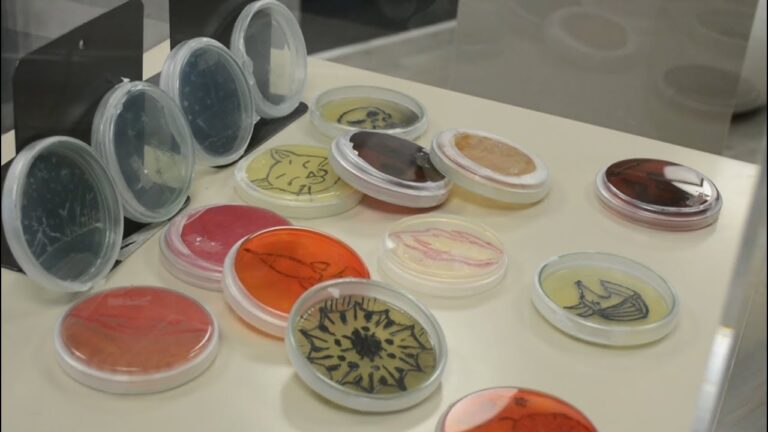
Beneficios de reservar libros en bibliotecas de Bogot&aacute;

Beneficios de reservar libros en bibliotecas de Bogotá
En este artículo exploraremos las ventajas de reservar libros en las bibliotecas de Bogotá. Descubre cómo este servicio te permite acceder a una amplia variedad de títulos de forma fácil y conveniente, ahorrando tiempo y dinero. ¡No te pierdas la oportunidad de aprovechar todas las ventajas que las bibliotecas de la ciudad tienen para ofrecer!
¿Cuáles son los beneficios de la biblioteca?
Las bibliotecas ofrecen una amplia gama de recursos educativos, desde libros y revistas hasta acceso a internet y programas de capacitación. Además, proporcionan un espacio tranquilo y acogedor para estudiar y realizar investigaciones, promoviendo así el crecimiento intelectual y la creatividad de la comunidad. En resumen, los beneficios de la biblioteca son invaluables para el desarrollo personal y cultural de las personas.
Además, las bibliotecas son fundamentales para preservar la historia y la cultura de una sociedad, albergando una gran cantidad de conocimiento que de otra forma podría perderse. Gracias a su labor de conservación y difusión del patrimonio cultural y científico, las bibliotecas contribuyen a la preservación de la memoria colectiva y al enriquecimiento de la identidad cultural de una comunidad. En definitiva, las bibliotecas son un tesoro invaluable que no solo enriquece a nivel individual, sino que también fortalece los lazos sociales y promueve el desarrollo de una sociedad más educada y consciente.
¿Cuál es el proceso para obtener el carnet de BibloRed?
Para obtener el carnet de BibloRed, simplemente completa el formulario de afiliación en línea o preséntate en uno de los puntos de afiliación en cualquiera de las 24 Bibliotecas Públicas. Una vez hecho esto, BibloRed se comunicará contigo para proporcionarte toda la información necesaria sobre tu afiliación. ¡Únete a la red de lectura más grande de Bogotá y disfruta de todos sus beneficios!
¿Qué nos ofrece la biblioteca pública?
La biblioteca pública nos ofrece una amplia variedad de recursos educativos y culturales para toda la comunidad. Desde libros de ficción y no ficción hasta revistas, periódicos y material audiovisual, la biblioteca es un lugar donde podemos encontrar información y entretenimiento de calidad de forma gratuita.
Además, la biblioteca pública organiza eventos y actividades para todas las edades, como clubes de lectura, talleres, conferencias y exposiciones. Estas iniciativas fomentan la participación y el aprendizaje continuo, creando un espacio de encuentro y enriquecimiento para la comunidad.
En resumen, la biblioteca pública nos ofrece un mundo de conocimiento y cultura al alcance de todos, promoviendo la educación, la creatividad y el diálogo entre sus usuarios. Es un lugar indispensable para el desarrollo personal y colectivo, que nos invita a explorar, aprender y compartir en un ambiente inclusivo y enriquecedor.
Accede a una amplia variedad de libros gratis
Descubre una amplia gama de libros gratuitos en nuestra plataforma. Desde clásicos de la literatura hasta obras contemporáneas, tenemos algo para cada lector. Con acceso ilimitado a nuestra biblioteca virtual, podrás sumergirte en historias emocionantes y aprender de autores destacados, todo sin costo alguno.
¿Quieres explorar nuevas historias sin gastar dinero? ¡Estás en el lugar correcto! Nuestra colección de libros gratuitos abarca todos los géneros, desde misterio y romance hasta ciencia ficción y biografías. No te pierdas la oportunidad de acceder a estos tesoros literarios sin tener que abrir la cartera.
Sumérgete en un mundo de conocimiento y entretenimiento con nuestra amplia variedad de libros gratis. Ya sea que busques un clásico atemporal o la última novela de un autor emergente, tenemos exactamente lo que necesitas. Disfruta de la lectura sin límites ni costos, solo en nuestra plataforma.
Ahorra dinero y espacio en tu biblioteca personal
¿Quieres ahorrar dinero y espacio en tu biblioteca personal? La solución es digitalizar tus libros. Con la tecnología actual, puedes llevar contigo cientos de libros en un solo dispositivo, ahorrando espacio en tus estantes y evitando gastos innecesarios en libros físicos. Además, al tener tus libros digitalizados, podrás acceder a ellos en cualquier momento y lugar, sin preocuparte por perderlos o dañarlos.
Digitalizar tus libros no solo te permite ahorrar dinero y espacio, sino que también te brinda la libertad de explorar nuevos títulos y autores sin tener que preocuparte por el espacio que ocuparán en tu hogar. Con una biblioteca digital, puedes organizar tus libros de manera eficiente, buscar rápidamente cualquier título y llevar contigo una amplia selección de lecturas a donde quiera que vayas. ¡No esperes más y comienza a disfrutar de los beneficios de una biblioteca personal digitalizada!
Apoya el acceso igualitario a la educación y la cultura
Apoyar el acceso igualitario a la educación y la cultura es esencial para el desarrollo de una sociedad justa y equitativa. La educación es la base para el crecimiento personal y profesional, y todos deberían tener la oportunidad de acceder a una educación de calidad sin importar su origen socioeconómico. Del mismo modo, el acceso a la cultura enriquece la vida de las personas, fomenta la diversidad y promueve la tolerancia y el entendimiento entre diferentes grupos sociales. Apoyar estas causas es fundamental para construir un mundo más inclusivo y justo para todos.
Es responsabilidad de todos trabajar juntos para garantizar que el acceso a la educación y la cultura sea igualitario. Esto incluye la implementación de políticas y programas que eliminen las barreras que impiden el acceso a la educación y la cultura para ciertos grupos marginados. Además, es importante promover la diversidad y la inclusión en los espacios educativos y culturales, para que todas las personas se sientan representadas y valoradas. Apoyar estas causas es un paso crucial hacia la construcción de una sociedad más igualitaria y justa para todos.
En resumen, reservar libros en las bibliotecas de Bogotá ofrece una serie de ventajas significativas para los lectores, como la comodidad de acceder a títulos populares, la posibilidad de planificar la lectura con anticipación y la oportunidad de disfrutar de un servicio gratuito y accesible para todos. Esta práctica no solo fomenta el hábito de la lectura, sino que también contribuye a enriquecer la experiencia cultural de la comunidad. ¡No pierdas la oportunidad de aprovechar este beneficio y disfrutar de todas las maravillas que las bibliotecas de la ciudad tienen para ofrecer!
